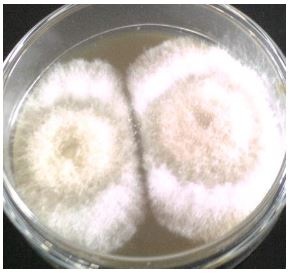
Colonias de hongos aislados en medio PDA, 8 das de incubacin a 25c.

Artículos
Patogenicidad de Beauveria bassiana (bals) vuill., sobre el gusano barrenador del loche Diaphania hyalinata (Lepidoptera: Pyralidae) en laboratorio
Pathogenicity OF Beauveria bassiana (bals) vuill. against the pumpkin plant butterfly Diaphania hyalinata (lepidoptera: pyralidae) in the laboratory
Patogenicidad de Beauveria bassiana (bals) vuill., sobre el gusano barrenador del loche Diaphania hyalinata (Lepidoptera: Pyralidae) en laboratorio
UCV-HACER. Revista de Investigación y Cultura, vol. 6, núm. 2, pp. 73-79, 2017
Universidad César Vallejo

Recepción: 15 Agosto 2017
Aprobación: 14 Septiembre 2017
Resumen: Los hongos entomopatógenos son parásitos obligados que causan enfermedades en varias órdenes de insectos, constituyendo una alternativa ecológica en el Manejo de plagas en diferentes cultivos agrícolas. En el presente estudio se determinó la patogenicidad de Beauveria bassiana, para su aplicación potencial como agente de control microbiológico contra larvas de tercer estadío del barrenador del Loche Diaphania hyalinata (lepidoptera: pyralidae) unas de las principales plagas del cultivo de Loche. El aislamiento evaluado fue de aplicación directa de suspensiones 10. y 1010 conidias/ml y registró una mortalidad en larvas de Diaphania hyalinata, entre 19% y 68% al cuarto día. En conclusión que la cepa Beauveria bassiana presenta un gran potencial en el control microbiano de Diaphania hyalinata.
Palabras clave: control microbiano, Beauveria bassiana, .iaphania sp., Loche..
Abstract: Entomopathógenic fungi are is obliged parasites that cause diseases in several orders of insects, constituting an ecological alternative in the pest Management in different agricultural cultures. In the present study, patogenicity of the Beauveria bassiana, for his potential application like microbiological control agent of against of the third instar larvae of the Pumpkin Plant butterfly Diaphania hyalinata (lepidoptera: pyralidae) some of the important pest of Pumpkin Plant butterfly. Isolation evaluated by direct application of conidias suspensions of 106 and 1010/ml and mortality registered on larvae of Diaphania hyalinata, between 19% to 68% in the four day. In conclusion the Beauveria bassiana presents a great potential as a microbiological control of Diaphania hyalinata.
Keywords: microbiology control, Beauveria bassiana, Diaphania hyalinata, pumpkin plant.
Introducción
El cultivo de Loche (Cucurbita moschata Duch.) se caracterizan por ser enredaderas, trepadoras o rastreras, de crecimiento rápido con hojas palmatilobadas, de largos tallos no leñosos, huecos, angulosos y tendencia a producir raíces en los nudos. El loche es una cucurbitacea natural del departamento de Lambayeque cuyo cultivo se circunscribe a la provincia del mismo nombre y a los distritos de Íllimo, Mórrope, Túcume y Jayanca particularmente; en la provincia de Chiclayo está en los distritos de Reque y Monsefú y también en el distrito de Pítipo, en la provincia de Ferreñafe.
Uno de los factores adversos para su cultivo de Loche son las plagas como: Gallina ciega (Phyllophaga sp), mosca blanca (Bemicia tabaci), Mosca Minadora (Liriomyza huidobrensis) y los barrenadores de frutos y tallos (Diaphania hyalinata y D. nitidalis). De todos ellos D. hyalinata llamado barrenador de tallos y frutos es la más importante, se alimentan de las hojas, flores y frutas, lo que puede causar defoliación. Minan los tallos causando la muerte de la porción distal, se alimentan de las flores o minan las frutas causando su caída o pudrición y pérdida de valor comercial.
La presencia de las larvas en las frutas se reconoce por uno o varios agujeros que exudan excremento de color naranja. Esta plaga se distribuye en Canadá, América del Sur y el Caribe según Cave, (1995). Las larva de D. hyalinata son de color verde pálido con dos rayas dorsales blancas pasan por cinco estadíos. En adulto es una mariposa algo vistosa, de color blanco y de pequeño tamaño (1,5 a 2 cm de largo y 2,5 cm de apertura alar) Sus alas están bordeadas por una franja oscura de 1,5 mm de ancho. El abdomen termina en un penacho blanco con forma de plumero. El huevo eclosiona alrededor de los 5 días y la larva demora de 9 a 14 días para convertirse en pupa, la cual a los 6 ó 7 días da lugar al adulto. Por lo tanto, el ciclo de vida dura entre
20 y 26 días, pudiendo dar un número considerable de generaciones en el año.
El control químico de esta plaga, se recomienda Insecticidas:
Cartap, Metamidofos, Metomil, Spinosad, Fipronil, Tiodicarb para tratamiento de guías antes de la siembra; mezclas: Metamidofos + Cyfluthrin efectivos para el control pero afecta a los polinizadores y con ello la producción de frutos. En el control biológico, se recomienda a Bacillus thuringiensis (cepa 13) y Metarhizium anisopliae (cepa Micotall) y no se ha reportado a Beauveria bassiana, una especie asociada al control de Lepidopteros y coleópteros.
B. bassiana, encontrados en insectos enfermos, antes de matar a su hospedero le causa síntomas importantes como son: pérdida de sensibilidad, inapetencia, melanización, parálisis falta de coordinación y letargo. Con la muerte del insecto, el beneficio se incrementa pues la esporulación y posterior dispersión del hongo, permite un control más allá de la aplicación (Estrada et al., 1997; Vargas, 2003; Malpartida, 2004).
En cuenta a lo anterior, se realizó el presente proyecto, con la finalidad de estudiar la cepa de B. basssiana en el control de larvas de D. hyalinata, evaluando su patogenicidad, sintomatología, sintomatología, efecto en la alimentación y caracterización morfológica. Estableciendo de esta manera si constituye o no, una alternativa eficiente de control microbiológico del “gusano barrenador del Loche”.
Métodos
Insecto plaga
Se colectaron larvas del 3er estadío de Diaphania hyalinata, de una planta de Loche semicultivada en los cercos de campos productivos de arroz del Sector el Pancal, ubicada Distrito de Pisci, Provincia de Ferreñafe - Lambayeque. No registraba ninguna aplicación de bioplaguicidas ni ningún otro plaguicida. Las larvas colectadas fueron colocadas en tapers ventilados y llevadas al laboratorio de la Universidad Cesar Vallejo, donde fueron evaluadas, siendo seleccionadas para el ensayo aquellas que mostraron mayor actividad y capacidad de alimentación.
Cepa de B. bassiana
La cepa usada en este estudio, fue aislada y seleccionada en el Laboratorio de microbiología de la Universidad Cesar Vallejo UCV- Campus Chiclayo y propagada en sustrato de arroz.
Reactivación de B. bassiana
Con el fin de recuperar la actividad metabólica del hongo y obtener cultivo puro en mayor proporción se utilizó Agar Papa Dextrosa (PDA), se extrajo micelio del cultivo inicial, se sembró en puntura y se incubó a 28+- 0.5°C.
Propagación y estandarización del inóculo Se preparó una suspensión de B. bassiana en solución estéril de Tween 80 al 0.1 %, se utilizó 0.1 ml de la suspensión del hongo, se incubó a 28°C hasta la formación de esporas. Posteriormente se les agregó una solución acuosas de Tween 80 al 0.1 % para obtener las esporas. La suspensión de esporas fue colocada en matraz estéril. Luego se estandarizó en cámara de Neubauer a las concentraciones de 10 ., 10. y 1010 las que sirvieron de inóculo.
Inoculación
La muestra estuvo constituida por 250 larvas de D. hyalinata, de las cuales 3 grupos de 25 larvas fueron ejemplares del problema y otro grupo de 25 larvas fueron ejemplares de testigo, realizando un total de 3 repeticiones. A los ejemplares del problema se les inoculó por sumersión una suspensión de esporas en Tween 80 al 0.1% a concentraciones de 10., 10. y 1010 esporas/ml de B. basssina mientras al testigo se le inoculo una solución acuosa de Tween 80 al 0.1%.
Evaluación de la actividad entomopatógena de B. bassiana
Después de la inoculación, se evaluó cada 24 horas la aparición de síntomas y/o signos de la infección mitótica que presentaron las larvas de los tratamientos en comparación con el testigo. La observación se realizó diariamente anotando la aparición de síntomas como pérdida de apetito, parálisis, pigmentaciones, u otros, que se produjo durante el ensayo, siendo el tiempo máximo de observación de 10 días.
Recuperación e identificación de B. bassiana
Con la finalidad de comprobar la causa de la muerte de larvas de D. hyalinata y consistió en colocar las larvas en cámara húmeda e incubando a temperatura ambiental, una vez emergido el hongo se extrajo con ayuda de un asa microbiológica y se sembró en tubo de ensayo con PDA para su posterior identificación de las estructuras características de B. bassiana.
Resultados y discusión Pruebas de Patogenicidad, sintomatología y alimentación
En la tabla 1, se presentan los porcentajes de mortalidad obtenidos en el presente trabajo. De acuerdo a lo obtenido, se observa que entre los tratamientos hay diferencias entre sí y con el testigo el cual no registró ninguna mortalidad durante el ensayo. Además que la mortalidad en los tres tratamientos fue directamente proporcional a la concentración de conidias, encontrando en el 4to día, el T3 fue el más efectivo con 68 %.

En la tabla 1 y figura 1, se observa que, la curva de mortalidad a través del tiempo, originada a dicha concentración fue diferente a las producidas por concentraciones de 10. y 10. conidias/ml, con las que alcanzó 68% y 19% de mortalidad respectivamente al cuarto día y 80% y 25% al quinto día posterior a la inoculación.

Estos resultado se aproximan con los obtenidos por otros investigadores, en otros lepidópteros bajo similares condiciones de laboratorio; así Malpartida, J. (2013) a una concentración de 10. conidias/ml obtuvieron una mortalidad de 84% en larvas de Dione juno; mientras que Quintana (2000), con 10.conidias/ml, logró un 100% de mortalidad en larvas de Rhyacionia buoliana Denis & Schiff (Tortricidae.). Por su parte Ávalos, K. (2014), con concentacion de 10. conidios/ml
y 10. conidios/ml, obtuvo el 78.5% y 85% de mortalidad sobre ninfas de Planococcus citri (Risso) a las 72 horas después de la aplicación respectivamente.
Estos resultados obtenidos expresan la efectividad del hongo B. bassiana sobre larvas de lepidópteros e indican que la concentración 1010conidias/ml con mayor efectividad para obtener resultados en el control biológico de plagas.
En cuanto al efecto del hongo sobre la alimentación, fue evidente observar la acción sobre las larvas de D. hyalinata, a partir del 2do día disminuyo considerablemente su apetito, al 4to día ya no se registra alimentación. El testigo a diferencia del tratamiento, mantuvo una tendencia creciente, en el consumo foliar; excepto al 4to día, que disminuyo, debido probablemente al envejecimiento de las larvas.
Tomando como patrón el consumo foliar del testigo en un 100%, en la figura 06, se observa la tendencia lineal decreciente en los tres tratamientos. Se puede observar que al día
siguiente de la inoculación, el consumo es casi el mismo, en todos los tratamiento del ensayo; pero a partir del 2do día las larvas expuestas al T3 presentan una reducción significativa del consumo foliar hasta en 50% con respecto al testigo, en el 4to día ya no se registra alimentación.
Con respecto a las demás concentraciones, también se aprecia un marcado efecto del hongo, lo que ocasiona una caída de alimentación que llega al cuarto día hasta el 60% y 80% en los tratamientos T1 y T2 respectivamente. Esta demuestra que a mayor concentración, mayor efecto del hongo, lo que origina en consecuencia mayor mortalidad.
Los resultados encontrados son parecidos con los reportados por Tefera & Pringle (2003), ellos reportaron que una concentración de 108 conidias/ml de B. bassiana en larvas de segundo estadío de Chiclo partellus (Pyralidae), el consumo de alimentos se redujo en 70-85 %, estos investigadores atribuyen importancia a esta reducción pues compensa la acción lenta de los hongos en su efecto mortal sobre el insecto. Según Alves, (1998) este menor consumo de alimentos, puede deberse a la producción de beauvericinas que actúan como inhibidores de la reacciones de defensa del hospedero, destruyen la hemolinfa y núcleos de las células.


Todas las larvas muertas y mantenidas en cámara húmeda, presentaron micelio entre el segundo y tercer día después de muertas confirmando a la cepa B. bassiana, como agente causal.
Caracterización fisiológica de la cepa B. bassiana
El crecimiento de las colonias de B. bassiana, en la mayoría de las placas, fue expansivo y homogéneo, en la figura 3se visualiza el crecimiento radial promedio durante los 10 días, con tendencia lineal conforme avanza los días. En promedio se registra 35 mm de desarrollo radial.
La cepa B. bassiana, demostró un porcentaje alto de germinación, con un promedio de 84.5%, lo que demuestra alta viabilidad de sus conidias.
Nuestros resultados también demostraron alta similitud con los reportados por los autores, para diferentes medios de cultivo, superando de todos ellos, el 90 % de germinación Elósegui & Elizondo, (2010).

Conclusiones
En condiciones de laboratorio la cepa B. bassiana fue patogénica sobre larvas de D. hyalinata en 3er estadío, alcanzando mortalidad del 100% con la concentración 1010conidia/ml; presentado una alta capacidad para disminuir fuertemente el consumo de alimentos al segundo día de aplicación.
La caracterización fisiológica de la cepa B. bassiana, presenta una buena calidad biológica, debido que presenta una germinación cercana al 90%, adicional buen crecimiento en medio de cultivo.
Los resultados de este ensayo, indican que B. bassiana, es una alternativa de control biológico, que debe ser incluido en el programa de manejo integrado de D. hyalinata, sobre todo si se tiene en cuenta las características del tegumento. Sin embargo se recomienda hacer ensayos previos, en condiciones de campo para determinar la concentración más óptima, así como las condiciones ambientales más favorables.
RECOMENDACIONES
Los resultados obtenidos de B. bassiana se constituye una alternativa de control para esta plaga, por lo cual se sugiere realizar pruebas en campo en los diferentes estadios de la plaga.
Es necesario realizar pruebas de compatibilidad con productos químicos usados en el cultivo de Loche afectado por esta plaga.
Referencias bibliográficas
Alves, S. (1998). Fugos entomopatógenicos. Control microbiano de insectos. 2nd ed. Fundación de Estudios Agrarios Luiz de Queiroz, Brazil.
Ávalos, L. (2014). “Efecto de Lecanicillium lecanii (Zimm) y Beauveria bassiana (Bals) Vuill. sobre Planococcus citri (Risso) en condiciones de laboratorio”. Tesis de grado, Universidad Nacional de Trujillo- Perú.
Ávila, R. (2013). Efecto de Beauveria bassiana, Metarhizium anisopliae, Isaria fumosorosea, y Lecanicillium lecanii sobre Oiketicus kirbyi “bicho del canasto” en condiciones de laboratorio. Tesis de grado Unibversidad Nacional de Trujillo- Perú.
Damas, G. (2012). Aislamiento y efectividad de Bb para el control biológicode la cucaracha urbana (Periplaneta americana). Tesis para grado de Doctor en ciencias, México.
Estrada, M., Romero, M. & Snowball, M. (1997). Aplicación de Beauveria bassiana en la lucha contra Diatraea saccharalis. Revista Caña de azúcar. Vol 15 (1). Instituto de Investigaciones de la Habana Cuba.
Gómez, H., Zapata, A., Torres, E. & Soberanis, W. (2007). Manual de producción y uso de Hongos entomopatógenos. Subdirección de Control Biológico-SENASA, Lima Perú.
Malpartida, J., Narrea, M. & Dale, W. (2013). Patogenicidad de Beauveria bassiana, sobre el gusano defoliador de Marcauya Dione Juno (Cramer)(Lepidoptera: Nymphalidae) en Laboratorio. Ecología Aplicada 12:(2). Lima Perú.
Nussenbaum, A. (2013) Aislamientos de Beauveria bassiana y Metarrhizium anisopliae para el control de picudo dl algodonero (Anthonomus grandis) (Coleoptero: Cucurlionidae).) Tesis para obtener grado de Doctor en ciencias biológicas, Universidad de Buenos Aires: Argentina.
Quiroz, D. (2013). “Efecto de Beauveria bassiana, Metarhizium anisopliae, Isaria fumosorosea, y Lecanicillium lecanii sobre Prodiplosis longifila “mosquilla del brote” en condiciones de laboratorio”. Tesis de grado, Universidad Nacional de Trujillo – Perú.
Toro, N. (2014). “Efecto de Beauveria bassiana y Lecanicillium lecanii sobre larvas de Heliothis virescens en condiciones de laboratorio”. Tesis de grado, Universidad Nacional de Trujillo – Perú.